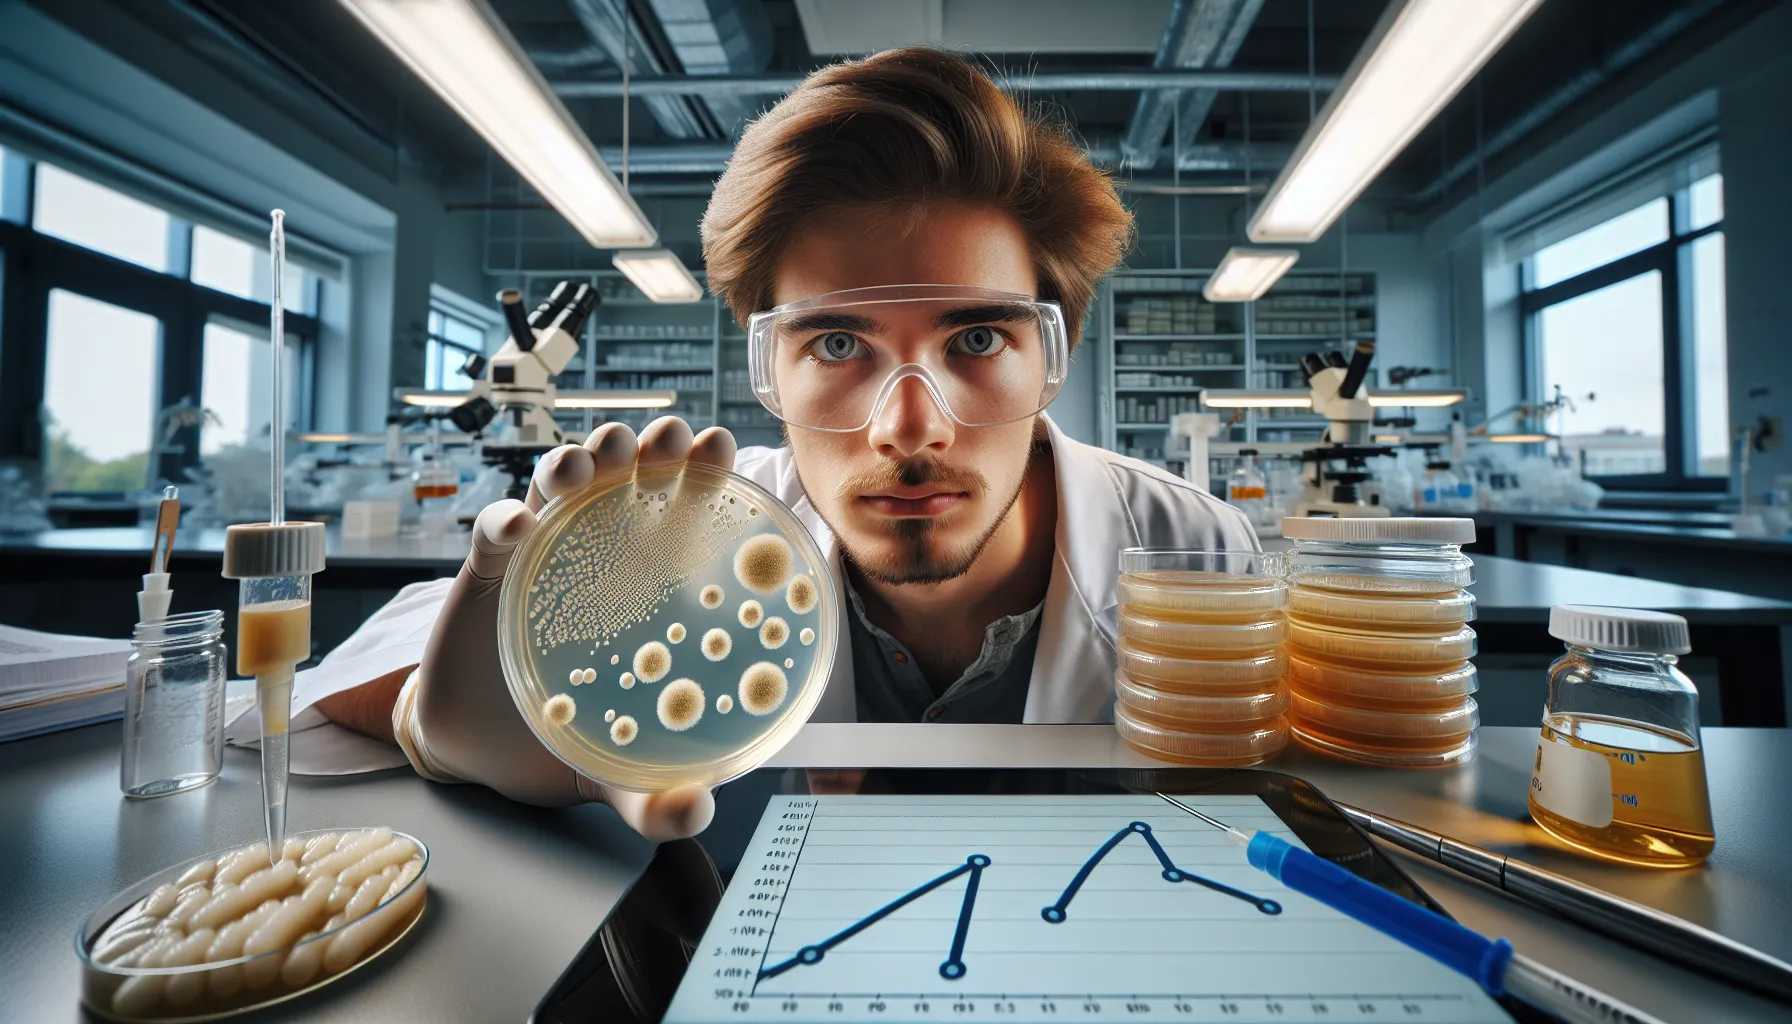
What Is Exponential Growth in Biology?

The Science Hub : News about online casinos
Don’t leave everything to Lady Luck. There are some things that you can take control of. Before betting on your first game, it should be your primary step to understand the machinations behind how casinos work. Learning this will give you a higher probability of winning or, conversely, help you lose less money than you need to in the long run.
The Team Behind Thesciencehub
We are a group of professionals, experts in the field, and ordinary people who are passionate about winning. We always aim for success and see ourselves as geniuses in the casino, second only to the big bosses. We here at Thesciencehub love sharing our knowledge and experiences from playing and betting on casino games. Our insights include tips from popular platforms like Lucky-7-Bonus Casino, where many of us have enjoyed engaging and lucrative gameplay.
So if you want to level up your game and not break bank, then our content is the perfect match for you.
Put Your Trust In Us
We know that you’re still wondering just what exactly we do. Well, read more to know about our behind the scene processes and pipeline to give you an idea that we look out for your best interests in gaming.

Expert Testing
Want to win big? Then learn only from the best in the biz! We have experts from the casino industry who help keep our team at Thesciencehub running smoothly. They test games and give their honest feedback about them. We aim not to use complicated mathematical computations or difficult diagrams to show results, so rest assured that you’ll easily understand our explanations. And our system is a combination of software-based applications and our elbow grease to test casino games.

Personal Trial
As casino enthusiasts, we are also experienced in spending our own time and capital to improve this casino game website. We do not earn anything from the tips we give; everything has been tested personally by us. We pledge to never recommend anything on our site that has not been tested by us previously.

Unbiased Reviews
One of our goals is to see you maximize your enjoyment of the games you choose to play. And we understand that many new players may doubt entering the game scene. So we remain transparent about casinos with bonuses, deals, free spins, special packages, and so on.
All for Free
All of our services are free. Developing this website and consulting our team comes with no cost for the readers. What a deal!
The content you can find here includes:
Casinos vs Players
Who has the edge? The gambler or the casino? We think that the answer is obvious, but research suggests that casino operators get more income year after year no matter where they are on the globe. Maybe this is because not enough people know insider casino info. What do you think?
Betting Strategies
This is defined as the tactic that lessens your losses and increases your wins on average. It is something you can control while not removing from the casino’s leverage. Some strategies might be based on your decisions to fold or increase your initial bets. Certain strategies can also include bluffing by doubling down. You can discover more about this with us.
There is No Other Place Like This
Due to the unique content of our site, we have no other competition on the internet right now. We offer vital resources for playing casino games, such as expert insights and results from testing a variety of games. A lot of players worldwide are curious about the probabilities and tactics to beat the odds of the dealer or house. And guess what? We provide answers to these questions for free!
Take Better Control of Your Gaming Life
Take a chance on us and check out our website!
- All Posts
- Blog

When I finished my biology degree, I remember staring at my diploma with two competing thoughts: I loved the science……

If you’ve ever knelt by a tide pool or watched a city park come alive at dusk, you’ve probably wondered…
The first time I watched yeast foam up in a warm sugar solution, I realized how quickly “a little” can…

If you’ve ever caught yourself staring at a droplet clinging to a leaf edge and wondered, Okay, but what is…

If you’ve been googling “how hard is AP Biology,” you’re probably staring at a course request form or a syllabus…

I still remember the first time I asked in lab, “So what is a buffer in biology, exactly?” The answer…

If you’re asking yourself, “is AP Biology hard?” you’re not alone, I hear that question all the time. My honest…

If you’ve ever wondered, “what is assimilation in biology?” you’re not alone, I’ve fielded that exact question from students, friends,…

I still remember the first time I “saw” crossing over, in a high school lab where we twisted two shoelaces…
